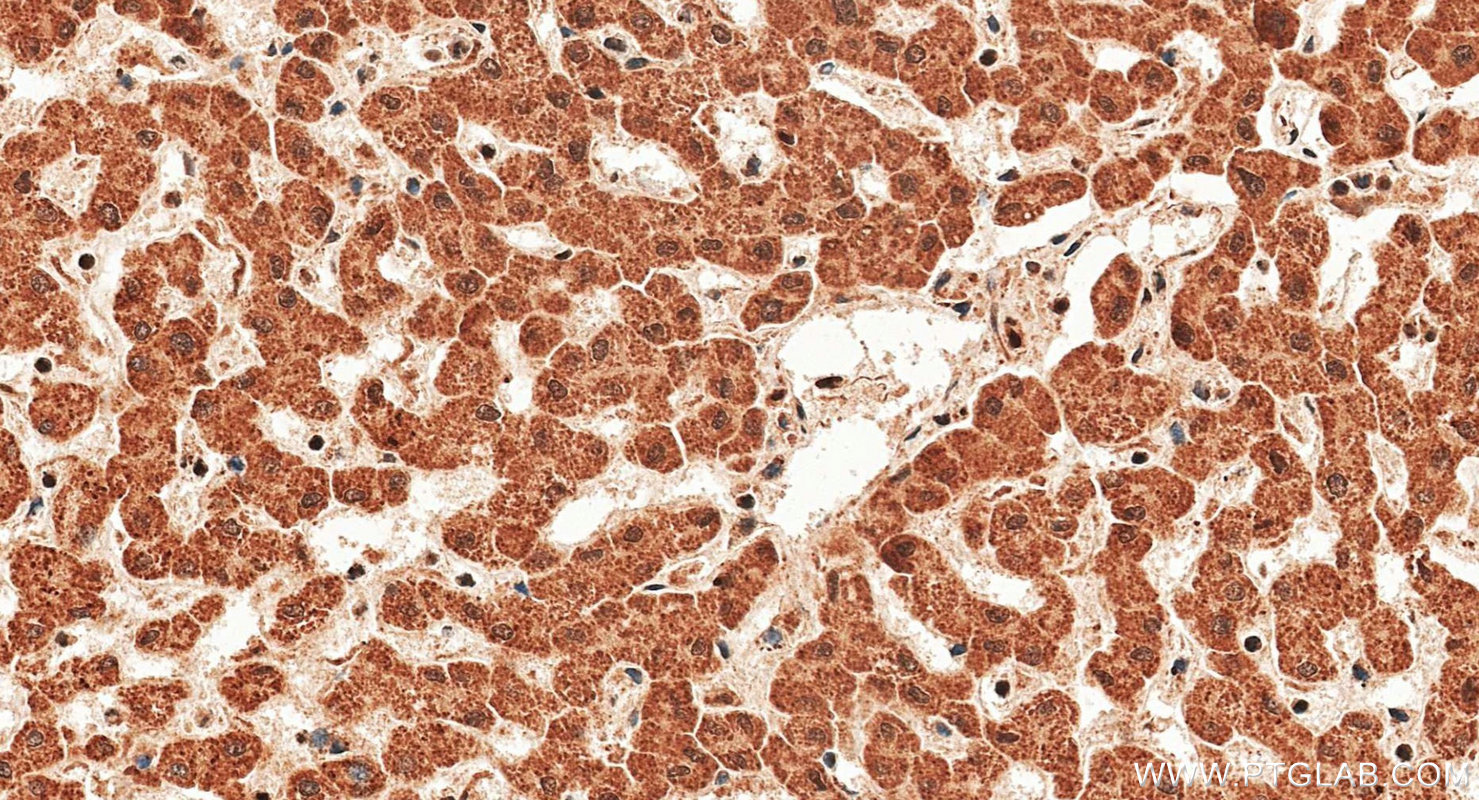
IHC staining of human liver using 18985-1-AP

验证数据展示
经过测试的应用
| Positive WB detected in | mouse liver tissue, rat liver tissue |
| Positive IHC detected in | human liver tissue Note: suggested antigen retrieval with TE buffer pH 9.0; (*) Alternatively, antigen retrieval may be performed with citrate buffer pH 6.0 |
| Positive IF/ICC detected in | HepG2 cells |
| Positive FC (Intra) detected in | HepG2 cells |
推荐稀释比
| 应用 | 推荐稀释比 |
|---|---|
| Western Blot (WB) | WB : 1:2000-1:10000 |
| Immunohistochemistry (IHC) | IHC : 1:250-1:1000 |
| Immunofluorescence (IF)/ICC | IF/ICC : 1:50-1:500 |
| Flow Cytometry (FC) (INTRA) | FC (INTRA) : 0.40 ug per 10^6 cells in a 100 µl suspension |
| It is recommended that this reagent should be titrated in each testing system to obtain optimal results. | |
| Sample-dependent, Check data in validation data gallery. | |
产品信息
18985-1-AP targets iNOS in WB, IF/ICC, FC (Intra), IP, ELISA applications and shows reactivity with human, mouse, rat samples.
| 经测试应用 | WB, IF/ICC, FC (Intra), ELISA Application Description |
| 文献引用应用 | WB, IF, FC (Intra), IP, ELISA |
| 经测试反应性 | human, mouse, rat |
| 文献引用反应性 | human, mouse, rat, pig, rabbit, chicken, bovine, goat |
| 免疫原 |
Peptide 种属同源性预测 |
| 宿主/亚型 | Rabbit / IgG |
| 抗体类别 | Polyclonal |
| 产品类型 | Antibody |
| 全称 | nitric oxide synthase 2, inducible |
| 别名 | NOS2, EC:1.14.13.39, Hepatocyte NOS, HEP-NOS, Inducible NO synthase |
| 计算分子量 | 131 kDa |
| 观测分子量 | 110-130 kDa, 65-70 kDa |
| GenBank蛋白编号 | NM_000625 |
| 基因名称 | iNOS |
| Gene ID (NCBI) | 4843 |
| RRID | AB_2782960 |
| 偶联类型 | Unconjugated |
| 形式 | Liquid |
| 纯化方式 | Antigen affinity purification |
| UNIPROT ID | P35228 |
| 储存缓冲液 | PBS with 0.02% sodium azide and 50% glycerol, pH 7.3. |
| 储存条件 | Store at -20°C. Stable for one year after shipment. Aliquoting is unnecessary for -20oC storage. |
背景介绍
NOS2, also named as iNOS and NOS2A, produces nitric oxide (NO) which is a messenger molecule with diverse functions throughout the body. NO is a reactive free radical which acts as a biologic mediator in several processes, including neurotransmission, antimicrobial and antitumoral activities. NOS2 is a nitric oxide synthase which is expressed in liver and is inducible by a combination of lipopolysaccharide and certain cytokines. iNOS has a very short half-life due to rapid degradation by calpain. iNOS monomer is a direct substrate of calpain I and can be cleaved by calpain I at the canonical CaM-binding site(503-532aa) of iNOS, and then a ~70 kDa band can be detected by western (PMID:11786228). This antibody is specific to NOS2.
实验方案
| Product Specific Protocols | |
|---|---|
| FC protocol for iNOS antibody 18985-1-AP | Download protocol |
| IF protocol for iNOS antibody 18985-1-AP | Download protocol |
| IHC protocol for iNOS antibody 18985-1-AP | Download protocol |
| WB protocol for iNOS antibody 18985-1-AP | Download protocol |
| Standard Protocols | |
|---|---|
| Click here to view our Standard Protocols |
发表文章
| Species | Application | Title |
|---|---|---|
Adv Mater Biomimetic Immunosuppressive Exosomes that Inhibit Cytokine Storms Contribute to the Alleviation of Sepsis. | ||
Bioact Mater Reprogramming macrophages via immune cell mobilized hydrogel microspheres for osteoarthritis treatments | ||
Adv Sci (Weinh) 3D Printing of a Vascularized Mini-Liver Based on the Size-Dependent Functional Enhancements of Cell Spheroids for Rescue of Liver Failure | ||
Adv Sci (Weinh) Reprogramming Lung Redox Homeostasis by NIR Driven Ultra-Small Pd Loaded Covalent Organic Framework Inhibits NF-κB Pathway for Acute Lung Injury Immunotherapy | ||
J Extracell Vesicles Extracellular vesicle-mediated delivery of circDYM alleviates CUS-induced depressive-like behaviours. | ||
Adv Sci (Weinh) Elevated Histone Lactylation Mediates Ferroptosis Resistance in Endometriosis Through the METTL3-Regulated HIF1A/HMOX1 Signaling Pathway |